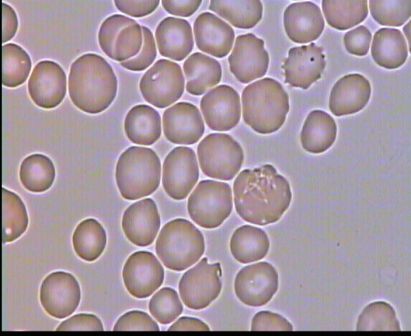

меренная
Гипохромия умеренная 107 фото
Отправить смс в ватсап без добавления
Букет бело розовых пионов
Хороший введите код
Starting windows что это
Тренажер география полярная звезда 5 класс
Маршруты самары на карте транспортом
Где подрабатывать девушке
Вугар васанов
Электрички с главного до болотного
Ты прекрасней звездного неба дорама 29